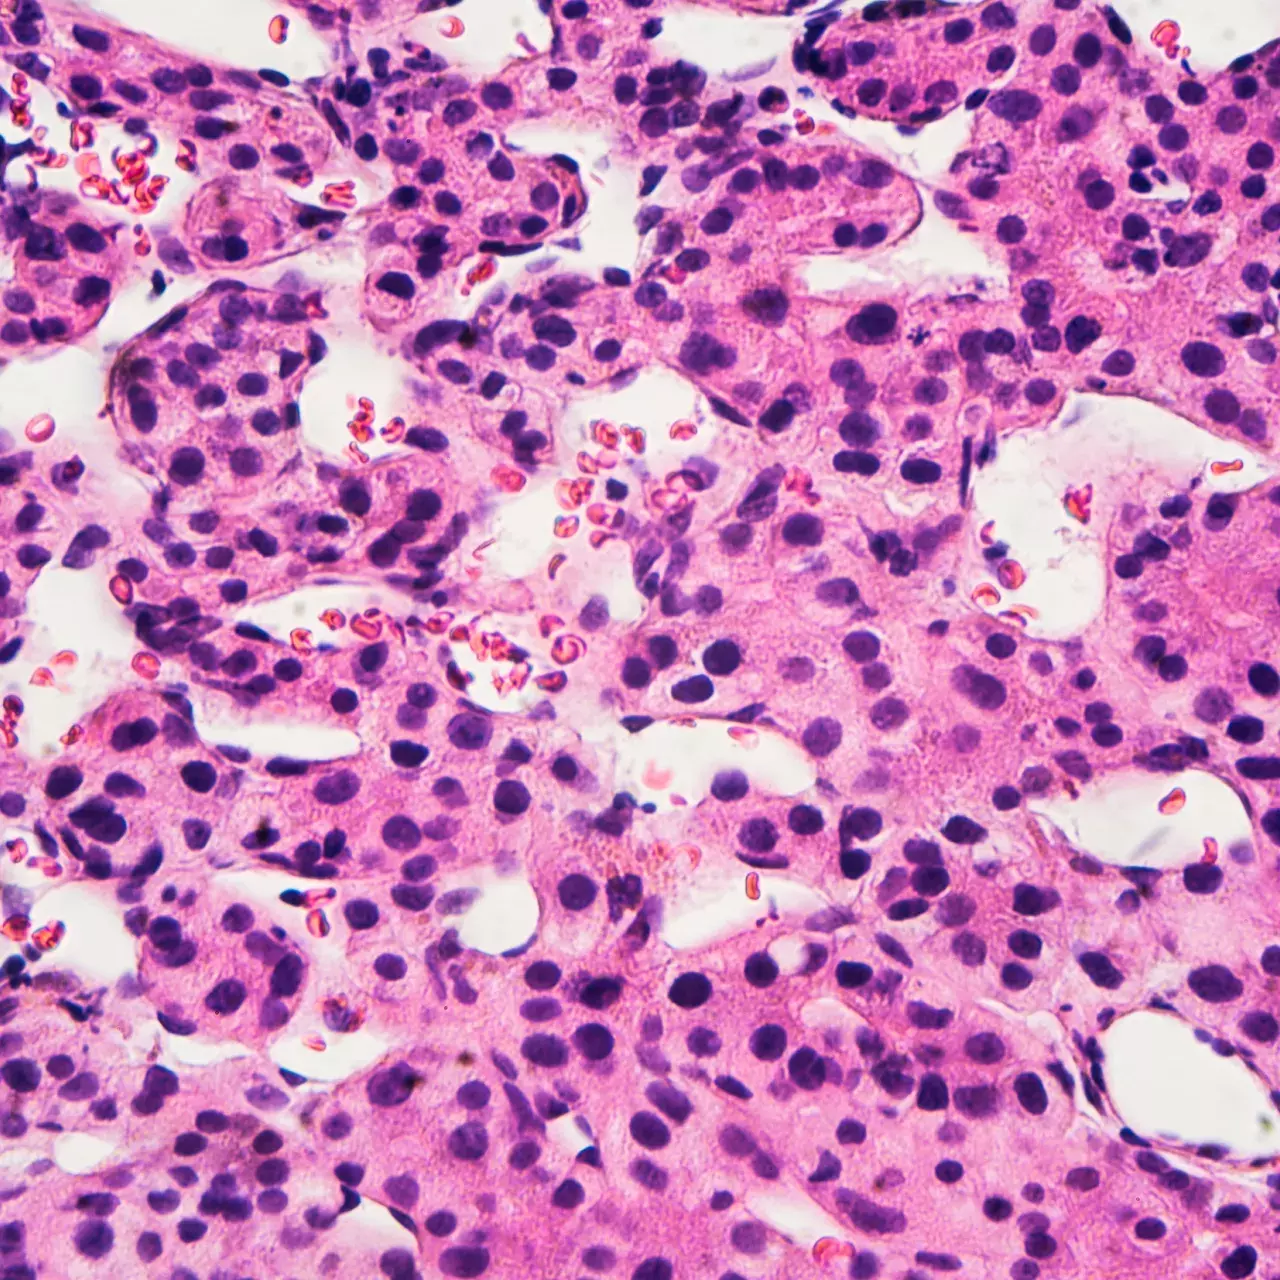
Cancer du foie

Chercher

Maladie d'Alzheimer
Lien confirmé entre le microbiote et le cerveau
87
87
%
des personnes hospitalisées acceptent de contribuer à la recherche
14
14
projets de recherche et développement financés par le Fonds de péréquation
ONCOLOGIE
Une combinaison optimale

Allergies
Ne pas se priver de toutes les noix

Diabète
Remettre les pendules à l’heure
1'246
1'246
articles publiés dans des revues à politique éditoriale
Génétique
17 anomalies à l’origine des anévrismes
2
2
jeunes chercheurs reçoivent une bourse attribuée par la Fondation privée
6
6
brevets déposés
21'044
21'044
personnes recrutées dans 933 études cliniques en cours